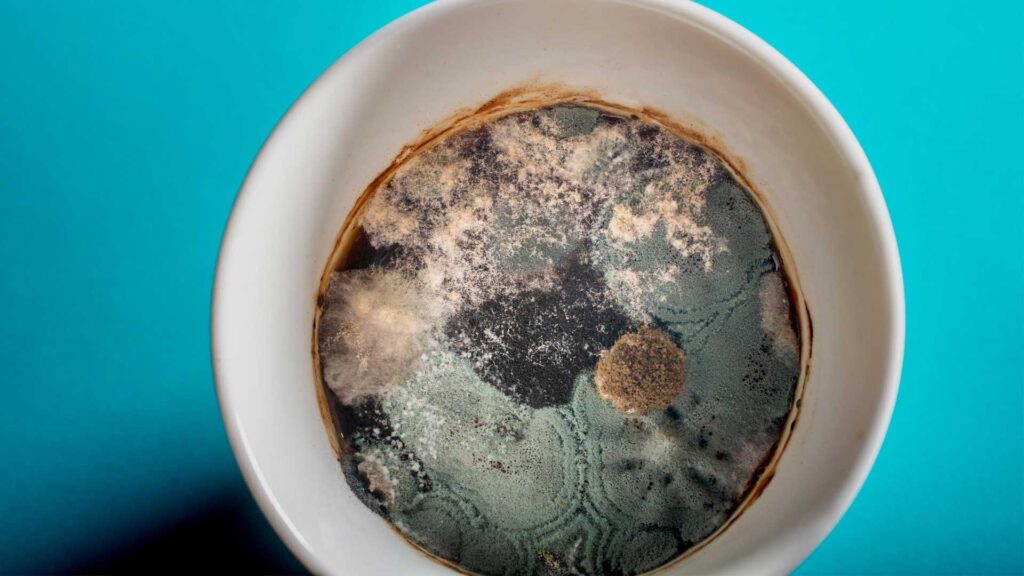

Are you always running late for work and missing out on your coffee? Maybe you should consider keeping some in the fridge!
But it might make you wonder how long coffee can stay in the fridge? Check out this article to find out!
How Long Does Coffee Last?
How long Does coffee last in the fridge? The answer isn’t quite as cut and dried as you might think.
It depends on your method of brewing, the coffee and water you use and what kinds of additives like dairy and sugar you put in your brew.
When it comes to putting coffee in the fridge there are a few things that you need to remember while storing it in the fridge. Read the next section to find out.
How Long Can Brewed Coffee Last in the Fridge?
Well it’s not a straightforward answer, therefore, the duration of brewed coffee in the fridge varies depending on factors such as brewing method, type of coffee and water used. But in some cases you can store your freshly brewed coffee of 4 hours.

1. Iced Coffee
Storing iced coffee is not recommended as it doesn’t taste as good as freshly made coffee.
Be sure to take out the ice cubes to prevent them from diluting and altering the flavor of your coffee. Save the ice cubes for when you are ready to enjoy your refreshing iced coffee.
2. Cold Brew
In contrast to iced coffee, cold brew concentrate can be stored in the refrigerator for as long as 10 days. Yet, if you dilute it with water first, its lifespan will be shortened to just 4 days.
Try freezing cold brew concentrate in an ice cube tray. Once the cold brew cubes are frozen solid, transfer them to a sealed container. By doing this, you can savor your cold coffee for a maximum of 2 weeks.
3. Stovetop Coffee
You can drink your favorite beverage even after a few hours after brewing and letting it completely cool down. Although it does not have the same effect as a hot cup of coffee, it is completely safe.
If you pour your coffee into a sealed container and store it in the fridge, it can last for 4 days.
4. Instant Coffee
Instant coffee is a type of ground coffee that has a longer shelf life. Some say that instant coffee can last for 2–20 years when stored properly — meaning in a sealed package or airtight container in a cool, dry, dark place.
5. Espresso
If you want to store espresso-based drinks like cappuccinos or lattes in the fridge, they won’t last long, especially compared to non-dairy coffee drinks.
It is advisable to consume dairy-based drinks within 2 days of refrigeration. Always remember to inspect the drink for any signs of spoilage, such as mold or change in color, even on the second day.
Factors Affecting How Long Coffee Stays Fresh?

Coffee thrives in darkness, cool temperatures, and dry atmospheres. These conditions ensure the exceptional taste and freshness that you savor with each sip. But what leads to the deterioration of your coffee’s flavor? Read this section to know about it
1. Light
The presence of light helps in the decomposition of the chemical compounds. This process is commonly known as Photo-degradation among scientists. Ultimately, the coffee will no longer retain its aroma and flavor.
2. Moisture
Coffee beans usually contain about 50% moisture, although, after processing and drying, the mixture reduces to about 10%-12%. The coffee beans could lose flavor when the moisture lowers below 8%
keep the coffee in a cool, dry container to avoid adding or reducing the existing moisture.
3. Heat
Another killer of refreshing aroma and taste is heating. You should keep roasted coffee beans away from heat until it’s time to brew them.
4. Oxygen
Coffee includes chemical compounds and acids grouped together as solubles. When coffee comes in contact with air, these solubles react with the oxygen in the air.
This reaction leads to the formation of new chemical compounds that alter the taste and aroma of the coffee.

Things To Follow To Properly Store Coffee In Your Fridge
Proper storage is essential for maintaining the freshness of coffee over time. Here are some ways to store coffee in fridge to keep it fresh for long time.
1. Ensure a tight seal: Make sure you coffee in an airtight container in the fridge to prevent exposure to light and air.
2. Avoid humidity and heat: Refrain from storing your coffee in the refrigerator or freezer, as this can introduce moisture. Opt for a dry location like a cabinet, which maintains a cooler temperature and darkness.
3. Purchase the right quantity: Buy only what you need for a few weeks at a time and consider a subscription service for regular replenishment. Avoid buying in bulk and storing in the refrigerator or freezer, as this can compromise the quality of the coffee once it is roasted.
Now, we will consider various situations to determine how the shelf life of coffee in the refrigerator is impacted. To begin with, pure black coffee will have a longer duration in the fridge compared to a sweetened and milked brewed coffee.
How Long Do Whole Coffee Beans And Coffee Grounds Last in the Fridge?

It’s equally important to mention here why storing coffee beans and coffee grounds in the fridge may not be a great idea.
The moisture and humidity inside a refrigerator can cause mold to grow and aroma and flavor to break down for ground and coffee beans in the fridge.
What is the shelf life of coffee pods when stored in the refrigerator?
Coffee pods are known for their exceptional taste and ease of use. What sets coffee pods apart is their ability to retain freshness until the expiration date.
Because each pod is tightly sealed, there’s no need to transfer them to a separate container. Just store them in a cool, dark place like a drawer to maintain or fridge their quality.
Note: Coffee should be stored in a cool, dark place in an airtight container. If you have excess coffee, you can also keep it in the fridge or freezer to last longer.
How Long Can You Keep Coffee with Milk in the Fridge?
Coffee with dairy has a shorter shelf life and should only be stored for 2 days. Once milk is added to coffee, it should be consumed within 2 hours to prevent bacterial growth.
If you love coffee and want to save it for the next day, you can store it in an airtight container in the fridge. It’s important to check for any signs of spoilage before drinking it.
Note: To keep your coffee fresh, store it in an airtight container and keep it in the fridge or freezer. Freshly ground coffee should be consumed quickly for the best flavor.

Risks Of Consuming Spoiled or Improperly Stored Coffee
Spoiled coffee may not be a major worry, but it could taste overly bitter and tart compare to fresh coffee.
The consequences of drinking bad coffee could vary if it was mixed with cream or milk. Spoiled milk is more likely to contain harmful bacteria that can cause food-borne illnesses.
What Happens If I Consume Spoiled Coffee?
To understand whether your coffee has gone bad, you should smell it for any distinct odor and check for any discoloration or mold formation.
If you drink spoiled coffee the next day or make coffee from old coffee beans, it’s usually not life-threatening. However, if your coffee has milk or creamer, there is a risk of foodborne illness.
A small amount of milk wouldn’t cause serious symptoms, but larger amounts of it may lead to an upset stomach, vomiting, and diarrhea.

Frequently Asked Questions
These are the most commonly asked question about coffee life in the fridge.
Q: How long can I keep my coffee in the fridge?
A: Black coffee can last about 3 to 4 days in the fridge when stored in an airtight container.
Q: Can I drink leftover coffee from the pot of coffee?
A: It’s generally safe to drink leftover coffee if it has been stored properly in the fridge, but its taste may deteriorate after a few days.
Q: Can cold brew coffee last longer than hot coffee?
A: Yes, cold brew coffee can last longer than hot coffee. When stored in the fridge, it can remain fresh for up to two weeks.
Q: How does black coffee taste after being in the fridge?
A: Black coffee that has been stored in the fridge may taste stale or flat after a few days, but it is still safe to drink if kept in an airtight container.
Q: Can I make coffee ice cubes for later use?
A: Yes, you can freeze coffee into ice cubes. This is a great way to keep your coffee fresh and can be used to cool down hot coffee without diluting it.
Q: How long can ground coffee stay fresh in the fridge?
A: Ground coffee can last about 1 to 2 weeks in the fridge if stored in an airtight container, but it is best consumed fresh for optimal flavor.
Q: What happens to coffee past its prime?
A: Coffee past its prime can taste bitter, stale, or lack flavor. It is best to drink coffee within a week for the best taste experience.

